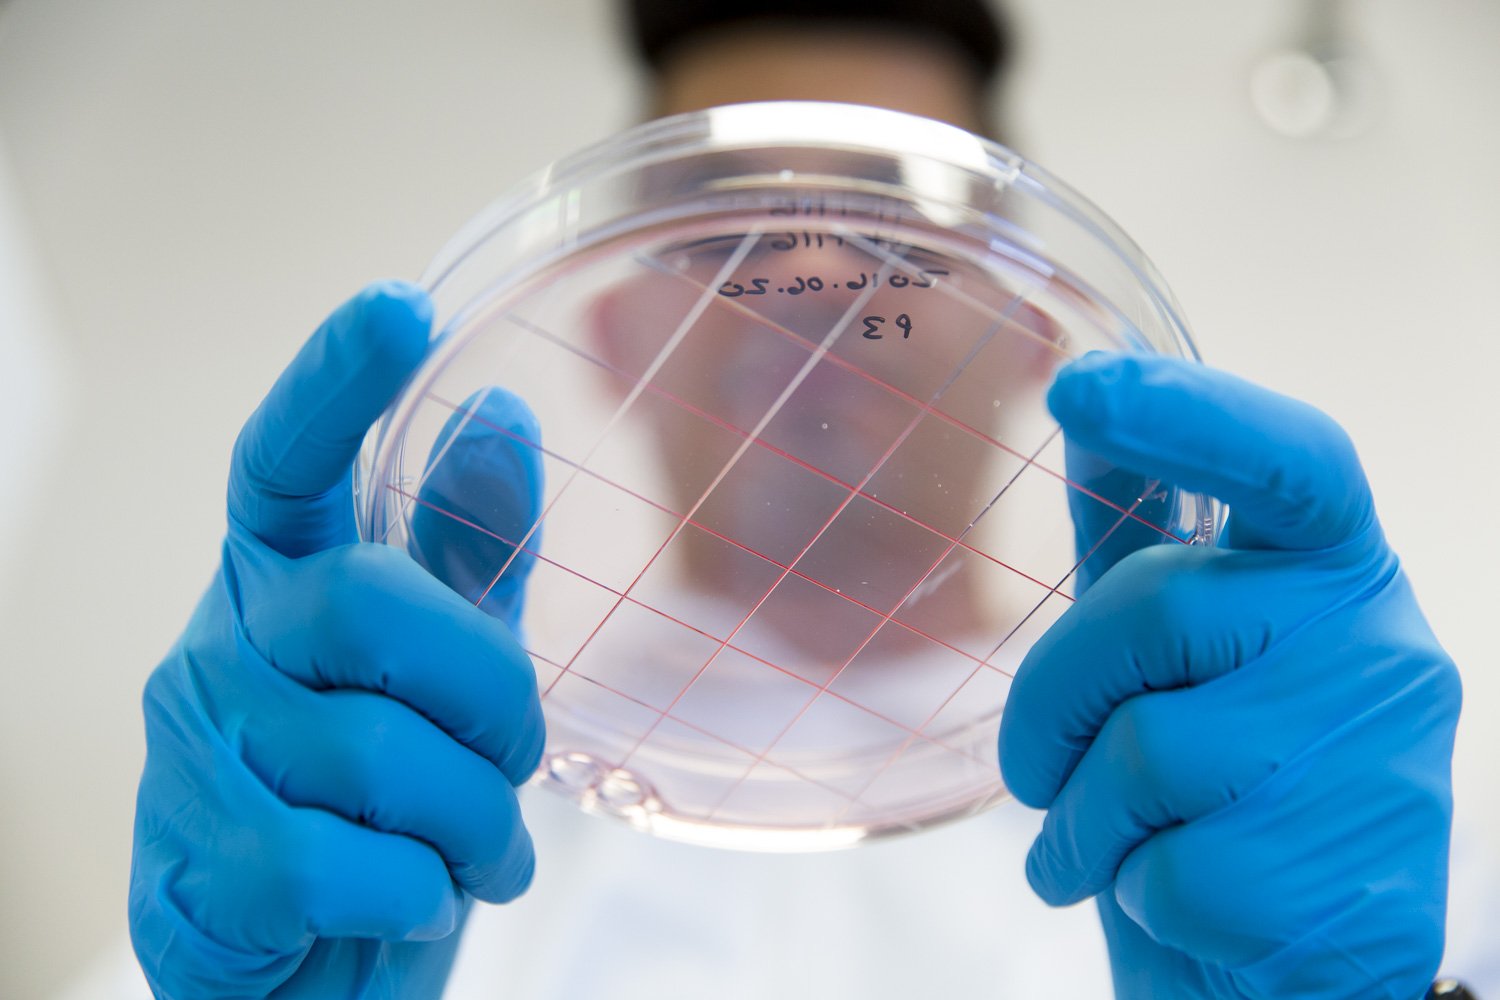

CORPORATE PHOTOGRAPHY

CORPORATE PORTRAITS

































